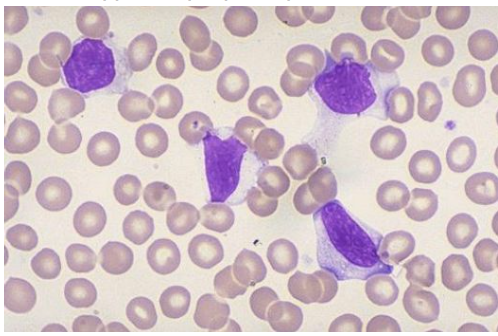

What is the Pathogen causes glandular fever?
-Epstein-Barr virus (EBV)- human herpes virus (majority cases)
What groups of people are most commonly affected?
Adolescents and children (mainly)
What is the incubation period for EBV?
Incubation period= 4-8 weeks
What symptoms may present if a patient has EBV?
Few symptoms. If any:
Mild fever/fatigue
Sore throat
Upper lid oedema
Nausea
Cough/photophobia
What investigations might you carry out to diagnose an EBV infection?
Investigation:
- Monospot test/Paul-Bunnell
- EBV specific antibody tests
- FBC
- PCR
- Throat Swabs
- 70-90% patients - produce IM heterophile antibodies
How is an EBV virus infection treated?
SUPPORTIVE: Avoid alcohol, Analgesia, Avoid contact sports (splenic rupture)
ANTIBIOTIC: Acyclovir
What are the possible complications due to an EBV infection?
Haemolytic Anaemia
Upper airway obstruction
Splenic rupture (rare)
Gastric lymphoma
What is the prognosis for an EBV virus infection?
- usually full recovery/asymptomatic
- splenic rupture if recognised quickly- prognosis good
- Fatigue and myalgia (pain in muscles) may persist after
What is the structure of the EBV virus?
Enveloped, dsDNA

What is the mechanism of action of the EBV virus?
Infects B cells, causes T cell proliferation
What diagnosis could be made by looking at this image?
EBV as- ATYPICAL lymphocytes


